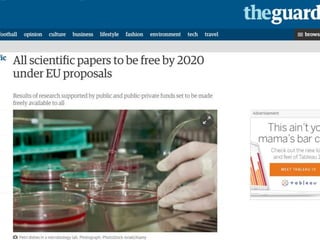

More Related Content
PPTX
オーブンデータによる大学Ir情報システムの可能性 プレゼン資料 PPTX
PPTX
PPTX
PDF
PPT
PDF
[Track3-4] アカデミックにおけるAI/ディープラーニング の教育と学習支援に関する研究 PPTX
What's hot
PDF
PDF
PDF
PDF
Music Visualization as User Interfaces PPT
PPTX
Viewers also liked
PPT
PDF
World Economic Forum Annual Meeting 2008 PPTX
Seminário 3 - Por uma prática docente crítica e construtiva DOCX
The analyis of IT industry in Romania PDF
3 Fierce Strategies to Thrive in Times of Change PPTX
It Takes an Ecosystem – How Brightspace and our partners are making education... PDF
3 Tips to Build an Accountable Culture PPSX
DOCX
PPTX
Online Marketing and Web analytics DOCX
Banana and cinnamon french toast recipe PPSX
Indonesia by Photographer David Lazar PDF
Mobile World Congress Keynote Speaker: Mark Zuckerberg PDF
Exploring the essence of spirituality 8 world views PPTX
Space Apps Tokyo 2016 Input Day Similar to H28 08-27 産学連携学会 第4回研究会(1h)
PPTX
H28.2.19 erms研究会 大学経営の鍵となるir PPTX
20150916 researchmapシンポジウム資料 PPTX
Researchmapシンポジウム2015資料 PDF
【報告】いきいき研究室増産プロジェクトFORUM2012 PDF
PPTX
PDF
H21年11月19日 日本学術会議公開シンポジウム PDF
PPTX
教員と職員のこれから from now on faculty and administrative staff PDF
第2回教育に関する懇談会_ 戦略的ベンチマークの取組から見えてきたこと PDF
PDF
国立大学法人等における学術情報基盤整備の方向性について PDF
PPT
PDF
いきいき研究室増産プロジェクトFourm2011報告書 PPT
2006年大学図書館職員講習会(短期研修)講義資料「大学図書館の現状と課題」 PDF
20230610ビジネス実務学会_基調講演.pdf PDF
PDF
Logic, Data Science and Institutional Research PDF
H28 08-27 産学連携学会 第4回研究会(1h)
- 1.
- 4.
- 5.
- 8.
- 12.
内容
1. イントロ
2. IRの意義と目的(一般論)
3.国内におけるIRへの期待
4. 事例紹介
① 出身高校分析
② 教育の国際化への取り組みに対するモニタリング
③ GPAまたは成績の平均点から何を読み取るか
5. おわりに
平成28年8月27日 第4回 産学連携学会 リサーチアドミニストレーション研究会 12
- 13.
- 14.
平成28年8月27日 第4回 産学連携学会リサーチアドミニストレーション研究会 14
2. IRの意義と目的
◇ 多くの大学では,各業務におけるIT化の進展。
2000年代以降の急速な電子化・ネットワーク化
教務,人事,財務・経理など
効率化が最大の理由
◇ 平成16年以降、新業務に大学評価が加わる。
大学の活動=文化的活動のアーカイブ
ステークホルダーへの説明責任
内部質保証(改善サイクル)の実質化
- 15.
平成28年8月27日 第4回 産学連携学会リサーチアドミニストレーション研究会 15
2. IRの意義と目的
◇ 内部質保証
機関の目的に沿って機関の活動をモニタし,必要な場合
は客観的データに基づき改善を行い,それを不断に継続
する。
1. 機関の目的や評価の基準
2. モニタリングの仕組み
3. 改善の仕組み
- 16.
平成28年8月27日 第4回 産学連携学会リサーチアドミニストレーション研究会 16
◆ 内部質保証を実質化するための機能=IR
◇ IRとは
“機関の意思決定や計画策定に資する
情報の提供“
J. Saupe 1990
2. IRの意義と目的
- 17.
- 18.
平成28年8月27日 第4回 産学連携学会リサーチアドミニストレーション研究会 18
2. IRの意義と目的(海外事例)
米国の場合
◦ 多くの大学は、学外からの各種データ提出に対応する集計作業。
◦ 州立大学システムでは、学生の成績データが州政府の高等教育局IRオ
フィスに一元的に集められる。
◦ 主に教育に関するデータとその分析
◦ 日本との違い「データは大学のものである」
事例1)ペンシルバニア州立大学
◦ Planning & Institutional Assessment
◦ 大学全体および、学内組織の計画立案および自己点検・評価の支援。
事例2)フロリダ州立大学
◦ データ収集とその提供に徹している。
◦ サービス対象は、管理職、一般教職員、学生におよぶ。
- 19.
平成28年8月27日 第4回 産学連携学会リサーチアドミニストレーション研究会 19
2. 国内におけるIRへの期待
さまざまな戦略的推進事業(文科省HPより転載)
(1)世界をリードする教育拠点の形成
博士課程教育リーディングプログラム
• 平成27年度予算額:178億円(平成26年度予算額:185億円)
→俯瞰力と独創力を備え、広く産学官にわたりグローバルに活躍するリーダーを養成するため、産学官の参画を得つつ、
博士課程前期・後期一貫した世界に通用する質の保証された学位プログラムを実施する「リーディング大学院」の構築を
支援する。
スーパーグローバル大学等事業
• 平成27年度予算額:87億円(平成26年度予算額:99億円)
→我が国の高等教育の国際競争力の向上及びグローバル人材の育成を図るため、世界トップレベルの大学との交流・連
携を実現・加速するための人事・教務システムの改革など国際化を徹底して進める大学や、学生のグローバル対応力育
成のための体制強化を進める大学を支援する。
大学の世界展開力強化事業
• 平成27年度予算額:24億円(平成26年度予算額:28億円)
→大学教育のグローバル展開力の強化を図るため、我が国にとって戦略的に重要な国・地域との間で、質保証を伴った
学生交流の実施等を推進する国際教育連携やネットワーク形成の取組を支援する。
•情報技術人材育成のための実践教育ネットワーク形成事業
• 平成27年度予算額:4億円(平成26年度予算額:5億円)
→情報技術を活用して社会の具体的な課題を解決できる人材を育成するため、大学や産業界による全国的なネットワー
クを形成し、実際の課題に基づく課題解決型学習等の実践的な教育を推進
- 20.
平成28年8月27日 第4回 産学連携学会リサーチアドミニストレーション研究会 20
さまざまな戦略的推進事業(文科省HPより転載)
(2)革新的・先導的教育研究プログラムの開発推進
地(知)の拠点大学による地方創生推進事業(COC+)
• 平成27年度予算額:44億円
大学教育再生加速プログラム(AP)
• 平成27年度予算額:12億円(平成26年度予算額:10億円)
大学間連携共同教育推進事業
• 平成27年度予算額:22億円(平成26年度予算額:24億円)
大学等における地域復興のためのセンター的機能整備事業
• 平成27年度予算額:10億円(平成26年度予算額:11億円)
産業界のニーズに対応した教育改善・充実体制整備事業
などなど、ほか高度医療人材育成関連事業にも5件。
平成27年度381億円。大学平均4700万円投資されている。
2. 国内におけるIRへの期待
- 21.
平成28年8月27日 第4回 産学連携学会リサーチアドミニストレーション研究会 21
「戦略」とは?
ー 特定の目的を達成するため、大局的・総合的な見地から活用可能な資源を効果
的に運用する方法。
そもそも大学には戦略という発想はなかった
ー 「特定の目的」というものがなく、学位を授与するための教育を実施し、各々の目
的に照らして研究活動を行っていた。
文科省からの資源配分の変化
ー 国立大の法人化および教育改革以後、競争的な資源配分への変遷。
ー テーマごとに目的志向の強い競争的資金事業による資源配分。
本丸は教育改革、国際化、ガバナンス強化
ー 自立的・自律的な大学のあり方に期待。
ー 客観的根拠に基づく大学経営を迫られている。
ー IRの必要性が強調される
私立大学等教育研究活性化設備整備費補助金
大学ガバナンス改革推進について(中教審大学分科会2014)
2. 国内におけるIRへの期待
- 22.
平成28年8月27日 第4回 産学連携学会リサーチアドミニストレーション研究会 22
IR(Institutional Research、機関研究・機関調査)
一般的定義
機関の計画策定や意思決定に資する情報の提供(Saupe 1990)
計画策定や意思決定 = 組織の執行部、経営者
情報の提供 = IR組織
• 単なる情報提供(米)のみならず、施策の提案なども期待(日)されている。
• 情報を収集して、課題に応じて分析し可視化する=インテリジェンス
国内のIRへの期待
教学 IR = 教育改善を目的としたIR
• 大学個別の取組み‥‥立命館大、京都工芸繊維大など
• 大学連携‥‥IRコンソーシアム、HATOプロジェクト等
• アンケート調査×成績情報(学生IDで結合)
研究IR=研究戦略(URA)
業務運営(評価)
データサイエンスを駆使、高度な問題解決能力への要求
2. 国内におけるIRへの期待
- 23.
平成28年8月27日 第4回 産学連携学会リサーチアドミニストレーション研究会 23
管理者 経営者
仲介者(IR)
質の高い
意思決定
McLaughlin と
Howardによる
情報支援サイクル
(1998)
2. 国内におけるIRへの期待
- 24.
平成28年8月27日 第4回 産学連携学会リサーチアドミニストレーション研究会 24
大学評価とIRは密接に関連している
◦ 大学基準協会:内部質保証(基準10)など
◦ それぞれの教育の取り組みが適切に検証されているか。
◦ 社会に対する説明責任や情報の公開がなされているか。
◦ 大学評価・学位授与機構:教育の内部質保証システム(基準8)
◦ 教育活動の自己点検評価と改善の仕組みの確立,機能。
◦ 教育に従事する者に対する改善の取組。
★ すべてデータに基づく客観的な点検評価が基礎
★ データがなければ評価は不成立→IRからのデータ提供
★ データ提供への理由づけとして評価対応は十分
2. 国内におけるIRへの期待
- 25.
平成28年8月27日 第4回 産学連携学会リサーチアドミニストレーション研究会 25
教育の目的
入学者
受入
方針
教育
課程
編成
方針
学位
授与
方針
IR:活動のモニタリング
(観測と分析)
デ
ー
タ
分
析
に
基
づ
く
評
価
と
改
善 教育の内部質保証:分析の枠組み
DWH
2. 国内におけるIRへの期待
- 26.
平成28年8月27日 第4回 産学連携学会リサーチアドミニストレーション研究会 26
2. 国内におけるIRへの期待
研究の目的
1.組織運営
(人・資金)
2.環境整備
(場所・設備)
3.研究
成果
IR:活動のモニタリング
(観測と分析)
デ
ー
タ
分
析
に
基
づ
く
評
価
と
改
善 研究の内部質保証:分析の枠組み
DW
H
学術的
インパクト
社会
関連性
質と量
- 27.
平成28年8月27日 第4回 産学連携学会リサーチアドミニストレーション研究会 27
2. 国内におけるIRへの期待
大学の目的
認証評価
中期目標
中期計画
IR:活動のモニタリング
(観測と分析)
デ
ー
タ
分
析
に
基
づ
く
評
価
と
改
善
業務運営の内部質保証:分析の枠組み
DWH
年
度
評
価
年
度
評
価
競争的資金に
よる大学事業
定
期
的
な
外
部
評
価
中間
評価
部局ごとの自
己点検・評価
- 28.
内容
1. イントロ
2. IRの意義と目的(一般論)
3.国内におけるIRへの期待
4. 事例紹介
① 出身高校分析
② ドロップアウト防止:成績の平均点の推移
③ ドロップアウト防止:修得単位と平均点の相関
④ 大学ランキング分析
⑤ 研究活動の活性化:機関の相対インパクト向上
5. おわりに
平成28年8月27日 第4回 産学連携学会 リサーチアドミニストレーション研究会 28
- 29.
4. 事例紹介
平成28年8月27日 第4回産学連携学会 リサーチアドミニストレーション研究会 29
① 出身高校分析
◦ 目的:定員充足のため、どの高校からの入学が多いかを把握する。
◦ 注意点:高校について個別に見るのではなく、全体の分布を俯瞰。
◦ 使用するデータ:15年分の学生の出身高校情報。
◦ 方法:各高校において5カ年で何人の学生が入学したかを集計。
◦ グラフ:集計値を降順に並べ替え、折線グラフで表記。
◦ 何がわかるか
特定の高校からの入学者の集中状況。
分布の変遷
- 30.
- 31.
- 32.
- 33.
4. 事例紹介
平成28年8月27日 第4回産学連携学会 リサーチアドミニストレーション研究会 33
① 出身高校分析
わかったこと
◦ 一極集中の減少
⇒ 入学後の学生の変化に現れてないか。
◦ 同じ高校であった学生の増加
⇒ 学内「独りっ子」生活への影響。
◦ 全体の状況を見るには、
⇒ 高校を特定せずに情報を圧縮する。
⇒ 棒グラフや折れ線グラフで簡単な可視化を試みる。
- 34.
平成28年8月27日 第4回 産学連携学会リサーチアドミニストレーション研究会 34
2. 事例紹介
② ドロップアウト防止
◦ 右のグラフは、ある資格取
得系の大学の3つのコース
における学生の成績平均
点の推移グラフ。
問「社会福祉士の成績が
良くない。なにが原因な
のか?
もしも改善できるのであ
れば施策は何か?」
70
72
74
76
78
80
82
84
1年次 2年次 3年次 4年次
3コース平均点推移
保健福祉士コース 保育士コース 社会福祉士コース
- 35.
4. 事例紹介
平成28年8月27日 第4回産学連携学会 リサーチアドミニストレーション研究会 35
問「社会福祉士の成績が
良くない。なにが原因な
のか?
もしも改善できるのであ
れば施策は何か?」
当該コースの学生の入学
時の成績については,問
題はなかった。
入学後の意欲低下がみら
れる(アンケート)。
なぜ意欲が低下したの
か?社会福祉士という資
格への理解が不足。
入試広報や高校説明会の
改善を図った。
70
72
74
76
78
80
82
84
1年次 2年次 3年次 4年次
3コース平均点推移
保健福祉士コース 保育士コース 社会福祉士コース
- 36.
4. 事例紹介
平成28年8月27日 第4回産学連携学会 リサーチアドミニストレーション研究会 36
③ ドロップアウト防止
単位と成績の相関
◦ 左のグラフは、各卒業生の
修得単位数と平均点につ
いて散布図にしたものであ
る(一つの点が独りの学生
を示す)。
問「単位が取れずに卒業
できない学生にばらつき
があるが、何か違いがあ
るだろうか?
また改善できる点はある
か?」
- 37.
4. 事例紹介
平成28年8月27日 第4回産学連携学会 リサーチアドミニストレーション研究会 37
問「単位が取れずに卒業で
きない学生にばらつきがあ
るが、何か違いがあるだろう
か?
また改善できる点はある
か?」
Aグループ
単位も取れておらず,各授業
についても成績が低い。
学習意欲向上などの取り組み。
Bグループ
各成績は良いのに単位が取
れていない。
不適合学生や経済的困難。
- 38.
4. 事例紹介
平成28年8月27日 第4回産学連携学会 リサーチアドミニストレーション研究会 38
④ 大学ランキング
THEもQSも大学が直接的努力(自力)でスコア向上に寄与でき
るのは,被引用数。
ただし,ランキングスコアから得られる分布からみて,かなりの
修正が加えられていることに注意。上位でも競争は激しい。
国際会議や学術雑誌に投稿するだけでなく,主催・編集側とし
て関与すれば,国際共著率の向上と,研究評判の向上に寄与。
教育評判や国際化指標の向上は制度的に難しい面がある。
- 39.
4. 事例紹介
平成28年8月27日 第4回産学連携学会 リサーチアドミニストレーション研究会 3939
教育評判 国際性 研究評判
被引用数
THE世界大学ランキングスコア分布(0〜100pt)
産業界から
の資金
総合
- 40.
40第4回 産学連携学会 リサーチアドミニストレーション研究会平成28年8月27日
20042005 2006 2007 2008 2009 2010 2011
京都大学 1.16 1.23 1.18 1.27 1.30 1.30 1.32 1.40
九州大学 0.98 0.99 0.99 0.96 1.00 0.92 0.93 1.09
大阪大学 1.24 1.17 1.19 1.18 1.27 1.29 1.36 1.51
東京工業大学 0.91 0.92 0.95 0.95 1.17 1.23 1.31 1.28
東京大学 1.28 1.26 1.33 1.28 1.42 1.42 1.56 1.58
東北大学 1.00 0.99 1.01 1.02 1.16 1.04 1.23 1.18
北海道大学 0.87 0.86 0.92 0.96 0.94 0.98 1.05 1.09
名古屋大学 1.07 1.08 1.09 1.08 1.35 1.23 1.45 1.43
京都大学, 1.40
九州大学, 1.09
大阪大学, 1.51
東京工業大学, 1.28
東京大学, 1.58
東北大学, 1.18
北海道大学, 1.09
名古屋大学, 1.43
0.70
0.80
0.90
1.00
1.10
1.20
1.30
1.40
1.50
1.60
1.70
対世界相対インパクト(1.00=被引用数世界平均)
国
内
8
大
学
研
究
力
分
析
⑤
相
対
イ
ン
パ
ク
ト
を
増
や
す
に
は
ど
う
す
れ
ば
良
い
か
- 41.
4. 事例紹介
平成28年8月27日 第4回産学連携学会 リサーチアドミニストレーション研究会 41
北海道大学 東北大学 東京大学 東京工業大学 名古屋大学 京都大学 大阪大学 九州大学
教員一人あたりの論文生産数 1.25 1.46 1.97 2.17 1.42 1.66 1.42 1.32
教員一人あたりの国際共著論文生産数 0.34 0.47 0.67 0.74 0.46 0.53 0.42 0.35
教員一人あたりの学生数 7.71 6.15 7.47 9.26 7.68 6.85 7.89 8.29
1.25
1.46
1.97
2.17
1.42
1.66
1.42
1.32
0.34
0.47
0.67
0.74
0.46
0.53
0.42
0.35
7.71
6.15
7.47
9.26
7.68
6.85
7.89
8.29
0.00
1.00
2.00
3.00
4.00
5.00
6.00
7.00
8.00
9.00
10.00
0.00
0.50
1.00
1.50
2.00
2.50
2012年 教員1人あたりの論文数(Web of Science) と学生数
教員一人あたりの論文生産数 教員一人あたりの国際共著論文生産数 教員一人あたりの学生数
教員一人当たりの学生数にはあ
まり関係なさそうだ
- 42.
42第4回 産学連携学会 リサーチアドミニストレーション研究会平成28年8月27日
20042005 2006 2007 2008 2009 2010 2011 2012
京都大学 5225 5329 5274 5439 5415 5551 5346 5779 5638
九州大学 2797 2966 3039 2836 2904 3000 2885 3060 3071
大阪大学 4417 4392 4576 4351 4570 4423 4349 4426 4427
東京工業大学 2679 2637 2544 2465 2547 2468 2388 2439 2372
東京大学 6956 6891 6718 7144 7013 7272 7337 7291 7470
東北大学 4336 4246 4445 4364 4303 4394 4309 4451 4380
北海道大学 2948 2938 2925 2882 2899 2849 2832 3030 2940
名古屋大学 2751 2745 2820 2851 2781 2826 2785 2920 3024
京都大学, 5638
九州大学, 3071
大阪大学, 4427
東京工業大学, 2372
東京大学, 7470
東北大学, 4380
北海道大学, 2940
名古屋大学, 3024
2000
3000
4000
5000
6000
7000
8000
年間総論文数
7大学+東工大 論文数 経年
論
文
の
絶
対
数
は
あ
ま
り
変
わ
ら
な
い
。
WebofScience
の
採
録
未
対
象
の
論
文
を
採
録
対
象
に
す
る
努
力
で
被
引
用
数
増
加
を
狙
う
。
- 43.
平成28年8月27日 第4回 産学連携学会リサーチアドミニストレーション研究会 43
まとめ
IRの一般的な定義
機関のデータセンターとしての役割
米国の一部ではプランニングと協働
国内の期待
効率的データ収集機能
素早いデータ分析
高度な問題解決技能
IRの事例
教育のIRについては、学生アンケートと成績情報の組み合わせ
手法については未だ開発途上
大学の文脈によって目的は大きく異なる
- 44.
平成28年8月27日 第4回 産学連携学会リサーチアドミニストレーション研究会 44
IRのその先
ネガティブイメージからポジティブイメージへ
教職員が活動の成果を実感できるポジティブな情報
例:研究者の活動+大学が運営する研究者情報DB
寄生虫の研究を癌の早期発見へ適用
例:とある大学の法学部の国際性
タイ国の行政,法曹界への人材育成
経年で変化を見る
誰に説明しているのか
大学業界の中だけで伝わるアカウンタビリティーから,国民が納得す
るアカウンタビリティーへ
国民(一般)の視点,国民に支持されること。
例:「はやぶさ」,「2位じゃダメなんですか」